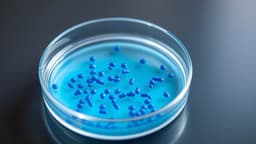
article image

Home / Health / Sugar's Secret Attack: Your Mouth's First Minutes
Sugar's Secret Attack: Your Mouth's First Minutes
2 Dec
Summary
- Bacteria convert sugar into acid within minutes, dissolving tooth enamel.
- Saliva and good bacteria combat acids, but can be overwhelmed by frequent sugar.
- Sugar fuels sticky biofilms, creating protective fortresses for harmful bacteria.

The moment sugar enters your mouth, resident bacteria begin consuming it, rapidly producing acids that can demineralize tooth enamel within minutes. Fortunately, saliva and competing oral bacteria naturally work to neutralize these acids and wash away sugars. However, consistent sugar consumption can overwhelm these protective mechanisms.
Harmful bacteria then exploit this by creating sticky biofilms, essentially fortresses on teeth that hinder saliva's effectiveness. These biofilms shield the bacteria, allowing them to thrive in acidic conditions while their beneficial counterparts perish. This environment promotes continuous acid production and mineral loss from teeth.
To mitigate this, reducing sugar intake, consuming sweets with meals to leverage saliva production, and avoiding constant sugary snacking are recommended. Regular brushing and flossing are crucial for removing plaque and preventing the formation of these protective bacterial fortresses, safeguarding your teeth.